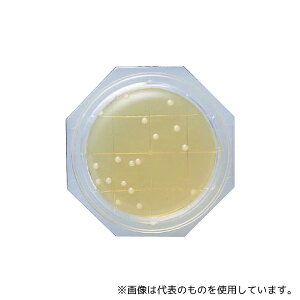
Ã_CAOmXeBNX 6786 N[X^vH10 SCDLPV|n 1(100)

「SCD」の人気商品一覧 | 安い商品を通販サイトから探す
622件 481〜520件を表示- 価格の安い順
- 価格の高い順
- 検索条件:
- その他の計測用具
- 本ページでは掲載するECサイトやメーカー等から購入実績などに基づいて手数料を受領しています。

その他の計測用具
型番SC-DMJK20 商品説明【特長】 受光棒2のオプションショルダーケース JK-20用 【仕様】 適用機種:DM-20
この商品で絞り込む
その他の計測用具
■HS-CD-W-50-K 電子式ホイストスケール HSシリーズ 検定付の特長 ●標準付属の無線式指示計で計量データー処理機能をプラス ●データー保存機能で最大9999件の計量データーをUSBメモリに保存できます。 ●演算、統計
![■FOLK ワンピース 3026SC Dネイビー×BW 3L 3026SC173L(6214158)[送料別途お見積り][法人限定][掲外取寄]](https://tshop.r10s.jp/first34/cabinet/6214/trusco-6214158.jpg?fitin=300:300)
その他の計測用具
オレンジブック トラスコ中山 TRUSCOFOLK ワンピース 3026SC Dネイビー×BW 3L 〔品番:3026SC173L〕[ 注番:6214158]特長●Aラインのシルエットで女性らしい印象のワンピースです。用途●病院、クリ...
この商品で絞り込む
その他の計測用具
■電子式ホイストスケール HS-CD-W-12の特長 ●標準付属の無線式指示計で計量データー処理機能をプラス ●データー保存機能で最大9999件の計量データーをUSBメモリに保存できます。 ●演算、統計機能で金額計算はもちろん、水
![■FOLK ワンピース 3026SC Dネイビー×BW M 3026SC17M(6217342)[送料別途お見積り][法人限定][掲外取寄]](https://tshop.r10s.jp/first34/cabinet/6217/trusco-6217342.jpg?fitin=300:300)
その他の計測用具
オレンジブック トラスコ中山 TRUSCOFOLK ワンピース 3026SC Dネイビー×BW M 〔品番:3026SC17M〕[ 注番:6217342]特長●Aラインのシルエットで女性らしい印象のワンピースです。用途●病院、クリニッ...
この商品で絞り込む

その他の計測用具
型番SC-DMDMNJK40 商品説明【特長】 デジボーオプション 【仕様】 適用機種:DM-40、DMN-40
この商品で絞り込む

その他の計測用具
高機能、高性能を追求したハイエンドモデル「Sラインシリーズ」です。別売のSラインダイヤルコンパレータ(KMC-1001)と組み合わせることで、高精度測定を実現します。【用途】内径測定用に■測定子: ルビー■取付可能測定器軸径: 8mm■
この商品で絞り込む
![■FOLK ワンピース 3026SC Dネイビー×BW LL 3026SC17LL(6214149)[送料別途お見積り][法人限定][掲外取寄]](https://tshop.r10s.jp/first23/cabinet/trusco/6214/trusco-6214149.jpg?fitin=300:300)
その他の計測用具
オレンジブック トラスコ中山 TRUSCOFOLK ワンピース 3026SC Dネイビー×BW LL 〔品番:3026SC17LL〕[ 注番:6214149]特長●Aラインのシルエットで女性らしい印象のワンピースです。用途●病院、クリ...
この商品で絞り込む
この商品で絞り込む
![■クボタ 防水・防塵直示式ホイストスケール500kg用(検定無し) HSCD05(4479611)[法人限定][直送元]](https://tshop.r10s.jp/first34/cabinet/4479/trusco-4479611.jpg?fitin=300:300)
その他の計測用具
オレンジブック トラスコ中山 TRUSCOクボタ 防水・防塵直示式ホイストスケール500kg用(検定無し) 〔品番:HSCD05〕[ 注番:4479611]特長●フレームは丈夫で壊れにくい鋳物を使用した堅牢設計です。●IP65の保護等...

その他の計測用具
特長 ●内径を高精度に測定 ●ミニインジケータSSI-250を搭載 → 高精度1/1000mm、ミニサイズφ45、超軽量75g ●アナログ表示で、基準ゲージとの差がみやすい ●MINモードで、内径の測定最小値をホールド ●JIS B ...

その他の計測用具
《仕様》●測定範囲:12〜20mm●測定子の有効ストローク:0.9mm●広範囲精度:3um●繰返し精度:0.5um●換えロッド:12、13、14、15、16、17、18、19、20mm●換えワッシャ:0.5mm●サイズ(幅×高さ×奥行...
この商品で絞り込む
![■クボタ 防水・防塵直示式ホイストスケール2000kg(検定無し) HSCD20(4479637)[法人限定][直送元]](https://tshop.r10s.jp/first34/cabinet/4479/trusco-4479637.jpg?fitin=300:300)
その他の計測用具
オレンジブック トラスコ中山 TRUSCOクボタ 防水・防塵直示式ホイストスケール2000kg(検定無し) 〔品番:HSCD20〕[ 注番:4479637]特長●フレームは丈夫で壊れにくい鋳物を使用した堅牢設計です。●IP65の保護等...

その他の計測用具
【ご注意】・商品画像はサイズ違いや色違いを含む代表画像(イメージ)を使用している商品がございます。 ・モデルチェンジ等により仕様や色等の変更が生じる場合がございます。・画像の商品数と販売数は異なる場合がございます。(例:

その他の計測用具
エビス 0120-18-5133 【商品説明】【特長】・いろいろな角度・勾配を測れます。・便利な目盛付きです。・カードサイズなので携帯に便利です。●本体仕様●水平・勾配・0〜45°測定可能●アクリル樹脂サイズ:5.5×54×86(m...
この商品で絞り込む

その他の計測用具
特長 ●耐久性に優れ、ワーク対応範囲の広いルビー測定子です。 ●熱膨張率の小さいインバー鋼をチューブに採用し、温度変化の影響を受けにくく、高品質が長く維持できます。内部の高精度伝達セグメントが、コンタクトピンの動きを反
この商品で絞り込む

その他の計測用具
ベクトン・ディッキンソン BD BBL(TM) γ線照射3 重SCDLP プラス寒天培地 90mm RT 1個(1本×120枚入)●ガンマ線照射3重包装された局方対応の無菌エリア環境用です。●中和剤としてレシチン、ポリソルベート及びチ...

その他の計測用具
【画像はイメージです】【納期について】発送日が配送予定を超える場合は、別途メールや問合せフォームにてご相談いたします。★数量・大口割引も受付中!お問い合わせください。 ■Sラインシリンダゲージ 151847 SCDI-160Sの特長 ...

その他の計測用具
【アズワン AS ONE】分析・特殊機器 分離・分析ロシ 分析機器その他 ●医薬品・化粧品検査用 商品の仕様 ●粉末 ●内容量:100g ●JANコード:4987026238432 【※ご注意ください】商品は代表の画像を使用しています。
この商品で絞り込む

その他の計測用具
※ 重量が10kgを超過、もしくは商品梱包が大型規格(梱包サイズ 縦・横・高さの合計が130cmを超過)の場合、追加送料が発生する場合があります。 台はかりでは計量しにくい長尺物や溶湯、農業のフレコンバッグなどを吊り下げて計量するの...

その他の計測用具
エビス 0120-18-5133 【商品説明】【特長】・いろいろな角度・勾配を測れます。・便利な目盛付きです。・カードサイズなので携帯に便利です。●本体仕様●水平・勾配・0〜45°測定可能●アクリル樹脂サイズ:5.5×54×86(m...
この商品で絞り込む

その他の計測用具
三脚をつけたままスムーズな移動 ■特長 ・折り畳み式キャスター付三脚用台車。 ・三脚を載せたまま移動できるのでスキャナの取り外し不要。 ・足で踏むだけで固定できるストッパー付。 ・持ち運びに便利なハンドル付。 ・ワンタッチで

その他の計測用具
【ご注意】・商品画像はサイズ違いや色違いを含む代表画像(イメージ)を使用している商品がございます。 ・モデルチェンジ等により仕様や色等の変更が生じる場合がございます。・画像の商品数と販売数は異なる場合がございます。(例:

その他の計測用具
【アズワン AS ONE】分析・特殊機器 分離・分析ロシ 分析機器その他 ●日本薬局方準拠培地 ●環境微生物検査用 ●一般生菌数測定用(不活化剤含有) 商品の仕様 ●培地表面積:25方センチメートル ●入数:30枚 ●重量:1020g...
この商品で絞り込む
![■FOLK ワンピース 3026SC Dネイビー×BW S 3026SC17S(6215774)[送料別途お見積り][法人限定][掲外取寄]](https://tshop.r10s.jp/first34/cabinet/6215/trusco-6215774.jpg?fitin=300:300)
その他の計測用具
オレンジブック トラスコ中山 TRUSCOFOLK ワンピース 3026SC Dネイビー×BW S 〔品番:3026SC17S〕[ 注番:6215774]特長●Aラインのシルエットで女性らしい印象のワンピースです。用途●病院、クリニッ...
この商品で絞り込む

その他の計測用具
●入数:1個 質量・質量単位 ●0.0g 【メーカー名】アズワン(株) 【メーカー品番】4-1435-07

その他の計測用具
特徴 いろいろな角度・勾配を測れます。 見やすい角度目盛り。 カードサイズなので携帯に便利です。 仕様 カラー:ホワイト×レッド サイズ(mm):5.5×54×86 重量:23g 体 水
この商品で絞り込む
その他の計測用具
【アズワン AS ONE】分析・特殊機器 検査用品 微生物検査用品 ●培地は面積10cm2の専用シャーレに盛り上がった状態で凝固されています。 ●培地を検体表面に直接押しつけることで検体採取することができます。 商品の仕様 ●生菌数用...
この商品で絞り込む

その他の計測用具
《仕様》●測定範囲:35〜60mm●測定子の有効ストローク:1.3mm●広範囲精度:3um●繰返し精度:0.5um●換えロッド:35、39、44、49、54、59mm●換えワッシャ:1、2、3mm●サイズ(幅×高さ×奥行):34×29...
この商品で絞り込む

その他の計測用具
■電子式ホイストスケール HS-CD-05-Kの特長 ●ハイレベルな精度、品質、機能で幅広い計量ニーズに対応 ●明るく見やすい大型赤色LEDを採用 ●IP65の防水・防塵設計 ●計量コンパクトでも堅牢ボディ ●
![クボタ 防水・防塵直示式ホイストスケール5000kg用(検定無し) HSCD50 [HS-CD-50][r22][s9-039]](https://img1.kakaku.k-img.com/images/category/search/loading.gif)
その他の計測用具
【直送品】【返品不可】【代引不可】【送料別途見積り】【車上渡し】 ■特長 ・防水・防じん設計で耐久性が飛躍的に向上しています。 ・軽量コンパクト設計・高精度です。 ・明るく見やすい大型LEDです。 ■用途<br

その他の計測用具
■電子式ホイストスケール HS-CD-30-Kの特長 ●ハイレベルな精度、品質、機能で幅広い計量ニーズに対応 ●明るく見やすい大型赤色LEDを採用 ●IP65の防水・防塵設計 ●計量コンパクトでも堅牢ボディ ●

その他の計測用具
■電子式ホイストスケール HS-CD-12-Kの特長 ●ハイレベルな精度、品質、機能で幅広い計量ニーズに対応 ●明るく見やすい大型赤色LEDを採用 ●IP65の防水・防塵設計 ●計量コンパクトでも堅牢ボディ ●

その他の計測用具
※車上渡し ●秤量(kg):1000●最小表示(kg):0.5●幅(mm):308●奥行(mm):351●高さ(mm):432●連続使用時間(h):約50時間●保護等級:IP65●センサー方式:ロードセル方式●検定:対象外●電源(V)...

その他の計測用具
●胴部分を4層構造(ラバー・ナイロンメッシュ・ラバー+吸汗メリヤス)にした強度に優れた長靴です。●つま先に鉄芯を入れた安全長靴です。●履き口のソフト合皮カバーにより異物の侵入を防ぎます。●裏面は滑りにくい彫刻構造です。
この商品で絞り込む

その他の計測用具
【メーカー名】 ●(株)ミツトヨ 【特長】 ●計測システム用ケーブル 【仕様】 ●コネクタタイプ:出力スイッチ付きストレート
この商品で絞り込む

その他の計測用具
特長 ●耐久性に優れ、ワーク対応範囲の広いルビー測定子です。 ●熱膨張率の小さいインバー鋼をチューブに採用し、温度変化の影響を受けにくく、高品質が長く維持できます。内部の高精度伝達セグメントが、コンタクトピンの動きを反
この商品で絞り込む
その他の計測用具カテゴリで検索されているキーワード:
お探しの商品はみつかりましたか?
検索条件の変更
ご利用前にお読み下さい
- ※ ご購入の前には必ずショップで最新情報をご確認下さい
- ※ 「掲載情報のご利用にあたって」を必ずご確認ください
- ※ 掲載している価格やスペック・付属品・画像など全ての情報は、万全の保証をいたしかねます。あらかじめご了承ください。
- ※ 各ショップの価格や在庫状況は常に変動しています。購入を検討する場合は、最新の情報を必ずご確認下さい。
- ※ ご購入の前には必ずショップのWebサイトで価格・利用規定等をご確認下さい。
- ※ 掲載しているスペック情報は万全な保証をいたしかねます。実際に購入を検討する場合は、必ず各メーカーへご確認ください。
- ※ ご購入の前にネット通販の注意点をご一読ください。
- ※ 本ページでは掲載するECサイトやメーカー等から購入実績などに基づいて手数料を受領しています。
- SCD
- DIY・工具
- 計測用具
- その他の計測用具の通販情報・価格比較
- 価格.com
© Kakaku.com, Inc. All Rights Reserved. 無断転載禁止

![アズワン AS ONE 【別途送料】 【個人宅不可】 低温冷凍冷蔵庫 SC-DF25 1-8757-01 [1445-0001373]](https://tshop.r10s.jp/daishinshop/cabinet/item/1445-1/1445-0001373.jpg?fitin=300:300)
